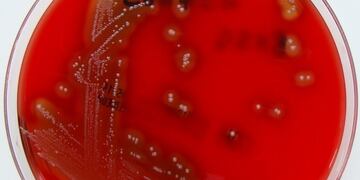
Imagen de la bacteria\u002E

Vía Santiago del Estero
Brandán le respondió a Gómez Ossola: "Trate de informarse respecto qué implica la ley"
La delegada del Inadi salió al cruce del religioso que había asegurado que la ley de Educación Sexual Integral era una estupidez auspiciada por la ideología de género.